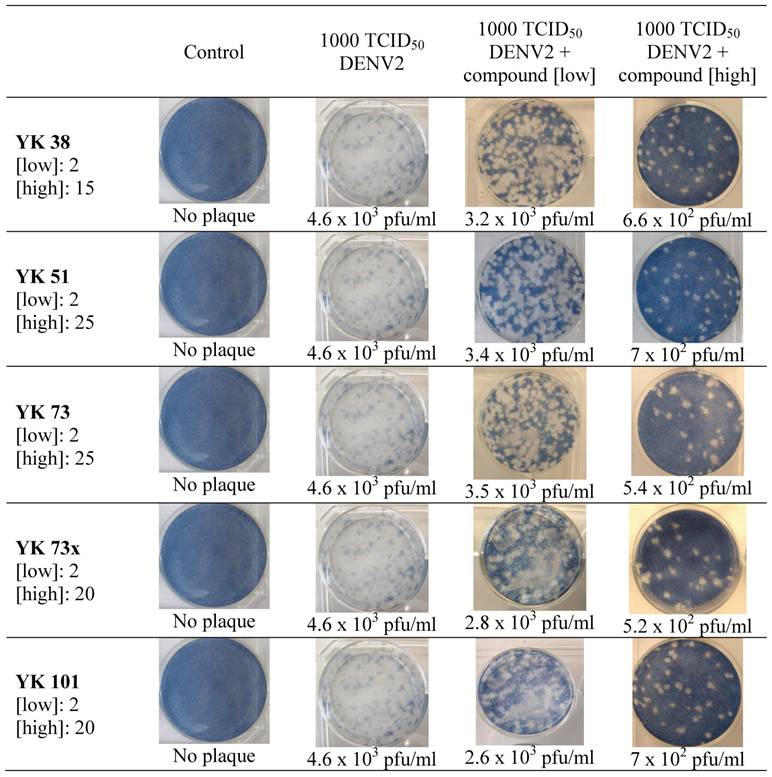
Int J Biol Sci Image

Impact Factor ISSN: 1449-2288
Int J Biol Sci 2010; 6(3):294-302. doi:10.7150/ijbs.6.294 This issue Cite
Research Paper
Antiviral actions of flavanoid-derived compounds on dengue virus type-2
1. Department of Molecular Medicine, Faculty of Medicine, University of Malaya, 50603 Kuala Lumpur, Malaysia;
2. Department of Chemistry, Faculty of Science, University of Malaya, 50603 Kuala Lumpur, Malaysia
Received 2010-3-7; Accepted 2010-5-19; Published 2010-5-23
Abstract
Dengue viruses, mosquito-borne members of the Flaviviridae family, are the causative agents of dengue fever and its associated complications, dengue haemorrhagic fever and dengue shock syndrome. To date, more than 2.5 billion people in over 100 countries are at risk of infection, and approximately 20 million infections were reported annually. There is currently no treatment or vaccine available for dengue infection. This study employed a whole-cell organism model or in vitro methods to study the inhibitory property of the flavanoid-derived compounds against DENV2 activity. Results showed that at concentration not exceeding the maximum non-toxic dose (MNTD), these compounds completely prevented DENV2 infection in HepG2 cells as indicated by the absence of cytophatic effects. The in vitro antiviral activity assessed in HepG2 cells employing virus inhibition assay showed high inhibitory activity in a dose dependent manner. At concentration below MNTD, compounds exhibited inhibitory activity against DENV2 with a range of potency strengths of 72% to 100%. The plaque forming unit per ml (pfu/ml) was reduced prominently with a maximum reduction of 98% when the infected HepG2 cells were treated with the highest non-toxic dose of compounds. The highly potent activity of the compounds against DENV2 infection strongly suggests their potential as a lead antiviral agent for dengue.
Keywords: Dengue virus type-2, flavanoid, cytophatic effects, in vitro inhibition, plaque assay, inhibitory activity
INTRODUCTION
Dengue is recently reported to be the most rapidly spreading mosquito-borne viral disease (1, 2) and is endemic in more than 110 countries with two-fifths of the world population at risk. An estimated 100 million cases of dengue fever and half a million cases of dengue haemorrhagic fever (DHF) occurred annually (3). The disease is caused by dengue virus which exists as four closely related, but antigenically distinct virus serotypes of DENV1 to 4 (4). This leads to many challenges in the development of a vaccine that would provide solid immunity equally to all serotypes (5). Another approach of viral diseases control is directed toward antiviral activities. Research for dengue antiviral has focused on the different phases of the viral lifecycle (virus attachment, viral entry, trafficking, translation or replication). Nevertheless, only few antiviral therapies have been tested and little is known about the effects and mechanisms of the antiviral agents (6).
This study aims to evaluate the in vitro inhibitory potential of a group of compound synthesized based on flavanoids of natural product template toward DENV2 infection using human cell culture model.
Materials and Methods
Cell culture
HepG2 hepatocellular carcinoma cells (from National Health Laboratory of Sungai Buloh Hospital, Selangor, Malaysia) and BHK21 cell derived from kidney of baby hamster were sub-cultivated regularly in a 1X concentrated growth medium of DMEM (GIBCO®) supplemented with 2 mM L-glutamine, 10% foetal bovine serum (FBS), 35 mM of sodium bicarbonate, 20 mM of HEPES buffer, 100 u/mL of penicillin G and 100 μg/mL of streptomycin at 37ºC in a humidified incubator with presence of CO2 at 5%. The C6/36 cells derived from the larvae of Aedes albopictus (from the laboratory of Medical Microbiology Dept., Fac. of Medicine, University of Malaya, Kuala Lumpur, Malaysia) were maintained in a 1X concentrated growth medium of Leibovitz's L-15 (GIBCO®) supplemented with 2 mM L-glutamine, 10% foetal bovine serum (FBS), 10% tryptose phosphate broth, 100 u/mL of penicillin G and 100 μg/mL of streptomycin at 28ºC in the absence of CO2.
Inhibitors
The synthesized compounds used in this study are shown in Table 1. The design and synthesis of these compounds have been reported elsewhere (7).
Chemical structures of the flavanoid-derived compounds.

Virus stocks
The dengue virus type-2 (DENV2) strain used in this study is a prototype of New Guinea C strain obtained from the Medical Microbiology Department in the Faculty of Medicine, University of Malaya. The virus stock was prepared by inoculating monolayer of C6/36 cells in a 25-cm2 tissue culture flask with virus diluted 1:5 to 1:10 in 1 mL of Leibovitz's L-15 containing 2% FBS. The flask was placed in an incubator at 28ºC to allow virus adsorption. After 1 hour, 4 mL of Leibovitz's L-15 supplemented with 2% FBS was added and the cells were allowed to continue propagating at 28ºC for 6 to 7 days until the cytophatic effect (CPE) are confirmed. The cells and supernatant were then harvested by gentle pipetting. Cell debris was removed by centrifugation at 1,500 x g for 5 minutes. The viral supernatant was collected in aliquots of 1 mL each and stored at -80ºC until further use.
Virus titration by plaque assay
DENV2 virulence was titrated by plaque assay using BHK21 cells as previously described (8). Briefly, BHK21 cell was seeded in 6-well plates (6 x 105 cells/well) in DMEM with 10% FBS for 24 hours at 37ºC. After cell propagation, growth medium was removed and serial dilutions of viral supernatants in DMEM with 2% FBS were added to the wells. The inoculated cells were further incubated to allow virus adsorption for 2 hours at 37ºC. Subsequently, a mixture of agar overlay was added and the plates were incubated at 37ºC for 5 days or until formation of plaque. The plaques were visualized after removal of the agar plug and staining with 0.1% naphthalene black solution in 6% acetic acid glacial. The virus titre is expressed as plaque forming unit (PFU) per millilitre.
Cytotoxicity screening of synthesized compounds
The in vitro cytotoxicity analysis was carried out on the synthesized compounds to determine the maximum non-toxic dose (MNTD) to HepG2 cells. Since these compounds were dissolved in methanol for testing, the cytotoxicity analysis is initiated with a control experiment using only methanol. The concentrated stock of compounds were mixed with DMEM of 2% FBS and made to different concentrations before added to preformed monolayer of HepG2 cells in 96-well plates. A series of suitable control for in vitro MNTD determination was included in every plate and the plates were incubated in the optimum environment for HepG2 cells. The MNTD of test compounds was analysed with a colorimetric assay using tetrazolium salt MTT at end-point of 96 hours post-incubation.
The in vitro inhibition assay
The in vitro inhibition assay of synthesized compounds was carried out in three sets of experiments with four replicates for each reaction. For each experiment, a 10-fold dilutions corresponding to 1000 - 10 TCID50 of DENV2 virus stock was prepared in DMEM with 2% FBS. Subsequently, preformed monolayer of HepG2 cells in either a 24-well plate (1 X 105 cells/well) or a 96-well plate (1 X 104 cells/well) was inoculated with serially diluted DENV2 for 1 hour at 37ºC with presence of CO2 at 5%. The reaction set up included control wells for the cells, virus and compound. Meanwhile, the concentrated stocks of the synthesized compounds were diluted with DMEM (2% FBS) to different concentrations within their respective maximum non-toxic doses range. At 1 hour post-infection, the cells were treated accordingly and incubated in the same environment.
The 24-well plate test groups were observed by phase contrast microscope on a daily basis for 4 days to detect any prevention of cytophatic effect (CPE) by the compounds. At post- 48 hours and 96 hours incubation time, the 96-well plate test groups were measured for the potency of inhibition using CellTiter 96® AQueous One Solution Cell Proliferation assay (Promega Corp.). At post- 48 hours and 96 hours incubation time, culture medium was collected from another 24-well test plate, aliquoted into several 1.5 mL Eppendorf tubes, labelled and kept at -80ºC for virus plaque assay.
Statistical analysis
Statistical analysis on the potency of inhibition was done using the Kruskal-Wallis test of SPSS version 17.0 software. It is a non-parametric test between groups analysis of variance which allows comparison of scores on continuous variable for three or more groups. The significance level, p less than 0.05 (p<0.05) or p less than 0.001 (p<0.001) will indicate significant difference in the continuous variable across the test groups.
RESULTS
Maximum non-toxic dose (MNTD) of synthesized compounds
The maximum non-toxic dose of methanol in HepG2 cells was determined prior to the cytotoxicity analysis. The MNTD for methanol was 6% (v/v) (Figure 1a). Thus, subsequently all compounds were prepared in methanol at concentrations lower than the methanol toxic dose. The relative toxicity plot against different concentrations of the five synthesized compounds revealed compound YK 38 to have the lowest maximum non-toxic dose at 15 μg/mL, making it relatively more toxic than all other synthesized compounds (Figure 1b).
Relative toxicity plot of methanol and the synthesized compounds. Cytotoxicity was measured at end-point 96 hours. All values are presented as means ± standard deviation of four replicates from two independent experiments. (a) The maximum non-toxic dose of methanol in HepG2 cells is 6% (v/v). (b): The maximum non-toxic doses were: YK 38=15 μg/mL; YK 51=40 μg/mL; YK 73=25 μg/mL; YK 73x=30 μg/mL and YK 101=25 μg/mL. Compound YK38 was found to be relatively more toxic compared with all the other synthesized compounds.

Antiviral activity of compounds YK 38, YK 51, YK 73, YK 73x and YK 101
(i) Absence of cytophatic effect
An example of established inhibitory activity is as shown in Figure 2 by compound YK 51. The HepG2 cells which were treated for 4 days with different non-toxic concentrations of the compound at 1 hour post-infection exhibited positive morphology characteristics. The antiviral activity of the compound was presented by the absence of cytophatic effects (CPE). Phase contrast microscope observation result showed preservation of the normal morphology of HepG2 cells which indicate prevention of DENV2 viral activity (Figure 2). Similar observation was seen in all infected HepG2 cultures that were treated with the rest of other compounds.
Morphological changes of infected HepG2 cells after compound treatment. HepG2 cells were inoculated with different titres of DENV2 and treated with compound YK 51 at post-infection (p.i) 1 hour. At concentrations below maximum non-toxic dose, the compound prevented DENV2 activity as depicted by the absence of cytophatic effect.

(ii) Potency of inhibition toward DENV2 infection
All inhibitory activities were then validated quantitatively via in vitro inhibition assay. A series of inhibition assays carried out using all five compounds revealed inhibitory activity toward DENV2 infection on a dose dependent response. As shown in Figure 3a, at non-toxic concentration of 5 μg/mL, YK 51 showed the highest inhibition activity at 92% against the highest DENV2 virus titre of TCID50 1000. Compound YK 73 was the second most potent inhibitor which showed 90% inhibition on DENV2 infection of 1000 TCID50 at 2 μg/mL. Another compound that exhibited high inhibitory potential of 91% was compound YK 73x. However, this compound required a higher concentration of 20 μg/mL for the same level of activity. This made compound YK73x slightly less potent than compounds YK 73 and YK 51. Compound YK 101 was able to prevent DENV2 infection of 1000 TCID50 by 80% at 10 μg/mL while compound YK 38 showed only 72% inhibition toward the highest DENV2 titre in HepG2 cells. The Kruskal-Wallis test (SPSS 17.0) indicated that all inhibitory percentage values were statistically significant with p value less than 0.05 (p<0.05) or 0.001 (p<0.001).
Inhibition profile of the synthesized compounds. All values are presented as means ± standard deviation of four replicates from two independent experiments. At different concentrations not exceeding the MNTD, all synthesized compounds prevented DENV2 infection at the whole range of virus titre. The highest inhibitory activities of each compound are: (a) YK 51; 92% inhibition against 1000 TCID50 of DENV at 25 μg/mL. (b) YK 73; 90% inhibition against 1000 TCID50 of DENV2 at 5 μg/ml. (c) YK 73x; 91% inhibition against 1000 TCID50 of DENV2 at 20 μg/ml. (d) YK 101; 94% inhibition against 10 TCID50 of DENV2 at 10 μg/ml. (e) YK 38; 83% inhibition against 10 TCID50 of DENV2 at 15 μg/ml.

(iii) Virus plaque assay of inhibitory activity
Virus plaque assay was performed on viral supernatants obtained from post-assay HepG2 cells described earlier. The results were tabulated in Figure 4 and observed to correlate with the inhibitory activity of test samples. The amount of virus plaques (expressed as pfu/mL) was markedly decreased by ten-fold when compounds were used at low and high concentrations not exceeding the maximum non-toxic doses.
Virus plaque assay following in vitro inhibition activity of synthesized compounds. All plaques were photographed and counted at day 5 of incubation. [ ] denotes concentration of compound in μg/ml; plaques are expressed as plaque forming unit per ml (pfu/ml)
DISCUSSION
Inhibition of DENV2 protease activities by two classes of natural products, the flavanones and chalcone extracted from an Asian fingerroot Boesenbergia rotunda has been reported in an earlier study (9). The bioactive natural products from the study are used as a template to design and synthesis new compounds that could possess inhibitory property toward dengue virus infection. The antiviral activity of these synthesized compounds was established in this study employing the cell culture system which reflects the virus-host interaction toward any effectors.
The cell culture system used for in vitro screening of the compounds and inhibition assay was the human hepatoma, HepG2 cells. These cells were chosen since cells of the hepatocyte lineage are implicated in the in vivo pathogenesis of DENV infection where patients with dengue fever and DHF often showed evidence of liver injury (10). Electron micrograph of HepG2 cells infected by dengue virus showed presence of intracellular virus particles originating from its replication site, the endoplasmic reticulum (11). Prior to screening, the pharmacological activity of the compound should be distinguished from being toxic to the cells. Results on the maximum non-toxic dose (MNTD) of these compounds indicated toxicity level at the high average value of 27 μg/mL. This suggests the compounds to be highly effective even at the lowest chemotherapeutic dose hence it is safe to be used for animal studies.
As observed in the results (shown in Figure 2), the synthesized compounds exhibited protective effect against DENV2 infection in HepG2 cells as indicated by the absence of cytophatic effect (CPE). CPE induced cells experienced massive morphological changes which often include increased in size (hyperthrophy) or necrosis presented as clear and opaque circles. Observations on HepG2 cells treated with non-toxic doses of these compounds at one hour post infection by various titres of DENV2 showed no characteristic changes in the cell. The normal state of HepG2 monolayer consisted of multipolar cells were completely preserved and remained intact throughout the test period.
A detailed evaluation on the inhibitory potential of all the compounds performed in the in vitro inhibition assay is adapted from previous studies (12, 13). In the in vitro assay, the inhibitory potential is calculated relative to the mitochondrial metabolic activity within the culture model. This activity is relative to the changes in cellular proliferation and viability due to infection and treatment of compounds. The cell viability was then measured quantitatively using the MTS tetrazolium reagent (CellTiter 96® AQueous One Solution Cell Proliferation Assay - Promega). The absorbance at 490nm is directly proportional to the number of living cells in culture, which relatively depicted the potency of inhibition by the compounds, and converted into percentage of inhibition comparative to the control. The measurement on the viability of the cells which indicated any value at or above 70% to be prominent and of good significance. Results showed that the synthesized compounds to inhibit DENV2 infection in a dose-dependent response in which all samples presented significantly high level of inhibitory activity. However, compound YK51 was found to be the most potent whereby in addition of being the least toxic with MNTD of 40 μg/ml, at a low concentration of 2 μg/mL, it has strong inhibition activity of 90% toward the highest virus titre of 1000 TCID50.
The inhibitory potential of compounds was also evaluated based on the value of DENV2 virus particles. Virus plaque assay has been considered the gold standard for antiviral susceptibility test (14). In this study, the technique was employed on culture medium retrieved from selected inhibitory assay. Results clearly showed that with increased dose of inhibitors, the forming of plaque was reduced. Compared with the inoculated monolayer of 4.6 X 103 pfu/mL, virus plaque count was reduced by ten-fold with treatment of the compounds.
Since all five compounds (YK 38, YK 51, YK 73, YK 73x and YK 101) were designed based on the same flavanoids as the template, it is expected that these compounds possess the same comparable level of activity against DENV2 infection. The functional group that is proposed to be important for the activity is identified as the saturated piperidine ring, which is the skeletal structure of all the compounds except in the case of YK 38. For YK 38, the unsaturated piperidine ring renders the conformation to be slightly different from the others. Presumably, this resulted in YK 38 to possess a different mode of action. Another functional group that was observed to be important for the activity of the compound is the carbamates or BOC (butylated oxycarbamates) group attached to the piperidinyl substituents. This functional group is present in compounds YK 51, YK 73 and YK 73x but not YK 101 where it is replaced by a hydrogen atom. Further study is needed to elucidate the mechanism of action by these flavanoid-derived compounds with relation to their molecular structure.
The results from this study have shown the inhibition of DENV2 in vitro by the synthesized compounds to be significant and hence they could potentially be considered as lead to a 'new' class of compounds as antiviral agent for dengue. In addition, new challenges arise in determining the mechanism of action against dengue by these compounds.
Acknowledgements
This work was supported by the Top-Down National Biotechnology Directory grant of Malaysia (09-02-04-001BTK/TH/004 [UM 36-02-03-6008]) and Science Fund from the Ministry of Science, Technology and Innovation, Malaysia (12-02-03-2005).
CONFLICT OF INTERESTS
All synthesized compounds used in this study have been submitted for Malaysia patent filing and the University of Malaya is the owner of the patent (Receipt No. : RST/IP-054844-2009). The university holds the rights for all the financial benefits that may result from this research.
References
1. Dengue Guidelines for Diagnosis, Treatment, Prevention and Control; New Edition 2009; A joint publication of the World Health Organization (WHO) and the Special Programme for Research and Training in Tropical Diseases (TDR). WHO. http://whqlibdoc.who.int/publications/2009/9789241547871_eng.pdf
2. Halstead SB, Heinz FX, Barrett ADT, Roehrig JT. Dengue virus: molecular basis of cell entry and pathogenesis, 25-27 June 2003, Vienna, Austria. Vaccine. 2005;23:849-856
3. Malavige GN, Fernando S, Fernando DJ, Seneviratne SL. Dengue viral infections. Postgrad Med J. 2004;80:588-601
4. Henchal EA, Putnak JR. The dengue viruses. Clin Microbiol Rev. 1990;3(4):376-396
5. Halstead SB, Deen J. The future of dengue vaccines. Lancet. 2002;360:1243-1245
6. Sampath A, Padmanabhan R. Molecular targets for flavivirus drug discovery. Antiviral Research. 2009;81:6-15
7. Lee YK. Synthesis for potential inhibitor as therapeutics agent against dengue virus protease (PhD Thesis). University of Malaya. 2010
8. Morens DM, Halstead SB, Repik PM, Putvatana R, Raybourne N. Simplified plaque reduction neutralization assay for dengue viruses by semimicro methods in BHK-21 cells: comparison of the BHK suspension test with standard plaque reduction neutralization. J Clin Microbiol. 1985;22:250-254
9. Tan SK, Pippen R, Yusof R, Ibrahim H, Khalid N, Rahman NA. Inhibitory activity of cyclohexenyl chalcone derivatives and flavonoids of fingerroot, Boesenbergia rotunda (L.), towards dengue-2 virus NS3 protease. Bioorg Med Chem Lett. 2006;16:3337-3340
10. Phoolcharoen W, Smith DR. Internalization of the dengue virus is cell cycle modulated in HepG2, but not Vero cells. J Med Virol. 2004;74(3):434-441
11. Marianneau P, Steffan AM, Royer C, Drouet MT, Kirn A, Deubel V. Differing infection patterns of dengue and yellow fever viruses in a human hepatoma cell line. J Infect Dis. 1998;178:1270-1278
12. Premanathan M, Kathiresan K, Yamamoto N, Nakashima H. In vitro anti-human immunodeficiency virus activity of polysaccharide from Rhizopora mucronata Poir. Biosci Biotechnol Biochem. 1999;63(7):1187-1191
13. Parida MM, Upadhyay C, Pandya G, Jana AM. Inhibitory potential of neem (Azadirachta indica Juss) leaves on dengue virus type-2 replication. J Ethnopharm. 2002;79:273-278
14. Wentworth BB, French L. Plaque assay of cytomegalovirus strains of human origin. Proc Soc Exp Biol Med. 1970;135(2):253-258
Author contact
Corresponding author: Mudiana Muhamad, Department of Molecular Medicine, Faculty of Medicine, University of Malaya, Kuala Lumpur, Malaysia 50603. E-mail: mudianamuhamadcom. Telephone: (603)79674716; Fax: (603)79674957

 Global reach, higher impact
Global reach, higher impact